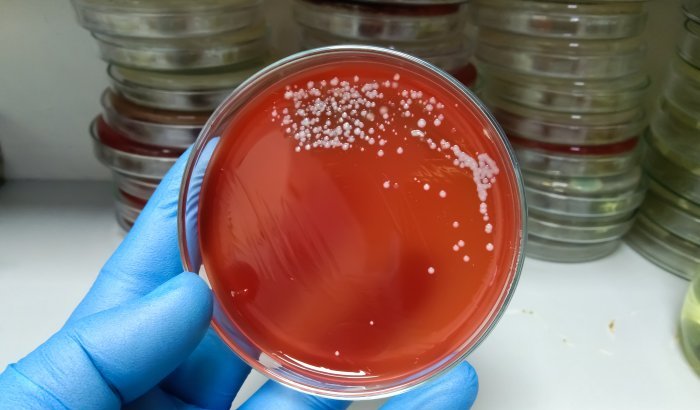

Los parlamentarios buscan establecer si la alerta epidemiológica de la cartera resultó oportuna luego que la OPS advirtiera el aumento de casos y muerte de pacientes en América Latina, en noviembre pasado.
Enviar un oficio a la Subsecretaría de Salud Pública para que entregue una serie de antecedentes sobre los casos Streptococcus Pyogenes (bacteria que agrava la influenza) y que se han registrado en el país en los últimos meses, así como, las medidas adoptadas por las autoridades, fue el acuerdo al que llegaron los integrantes de la Comisión de Salud.
Los parlamentarios se encuentran en alerta al triplicarse los casos de la denominada “bacteria asesina” que ha sido la responsable de diversas muertes de pacientes que han contraído influenza. La responsable de dicha subsecretaria, Andrea Albagli se refirió a esta situación tangencialmente cuando detalló la campaña de vacunación.
Ahora -dadas las estadísticas entregadas por el Ministerio de Salud (Minsal)- la Comisión planteó volver a invitar a la autoridad de manera de complementar el oficio solicitado. El documento remitido solicita un desglose de casos de esta bacteria por región, tanto sospechosos como confirmados más la descripción de las medidas implementadas desde noviembre del año pasado.
Cabe consignar que el Streptococcus Pyogenes es una bacteria que puede producir un amplio espectro de enfermedades, desde faringitis aguda o infecciones en la piel hasta infecciones graves de riesgo vital. Se transmite principalmente a través de gotitas respiratorias y el contacto directo con personas y superficies infectadas. Los grupos más afectados son niños preescolares y adultos mayores.
ALARMA PÚBLICA
En la sesión del 11 de junio, el presidente de la Comisión, el senador Javier Macaya afirmó que “es de total sentido el oficio. Es un tema que concita muchísima preocupación y es importante ver cuáles van a ser las actitudes que va a tomar el Minsal respecto a este tema”.
El senador Juan Luis Castro expresó que “hay un conjunto de situaciones, como la ocurrida, por ejemplo, durante este fin de semana en la ciudad de Copiapó, con el fallecimiento de un niño de 11 años, o en Temuco, donde también se demostró que dos menores habían sido afectados por esta bacteria, con coinfección de influenza tipo A”.
“En estos casos, y dado que esto ha generado alarma pública, y se ha decretado una alerta sanitaria, el 27 de mayo. Creo que es pertinente que la autoridad explique, además, por qué, desde el 23 de noviembre pasado, cuando la OPS estableció una alerta para las Américas en materia de Streptococcus Pyogenes, dicho acto se ejecutó seis meses después en nuestro país”, expresó.
Por su parte, el senador Francisco Chahuán manifestó que la alerta sanitaria a su parecer “fue tardía”, por lo que además del oficio, propuso que la subsecretaria Andrea Albagli fuese también citada para que diera a conocer las medidas que se están adoptando.
CASOS
De acuerdo al informe del Minsal entregado la primera semana de junio, se habían detectado 191 casos provocados por esta infección durante los primeros cinco meses del año, es decir, 189% más si se compara con el mismo periodo de 2023. El 5 de este mes, la titular de salud, Ximena Aguilera confirmó al menos 6 muertes por cuadros de influenzas asociados a la bacteria asesina.
En mayo, las regiones de Ñuble y de Los Lagos emitieron una alerta epidemiológica regional, en el primer caso por la gravedad de los cuadros y en el segundo, por el aumento de casos observados en la provincia de Osorno.
Asimismo, en noviembre del año pasado, la Organización Panamericana de la Salud (OPS) había emitido una alerta indicando que “en noviembre de 2023, Argentina informó de un aumento significativo en la notificación de casos y fallecimientos por este agente. Ante esta situación, la OPS/OMS recomienda a los estados miembros realizar la vigilancia clínica y genómica, así como a garantizar el diagnóstico precoz y tratamiento oportuno de los casos de enfermedad invasivas por streptococcus del grupo A”.